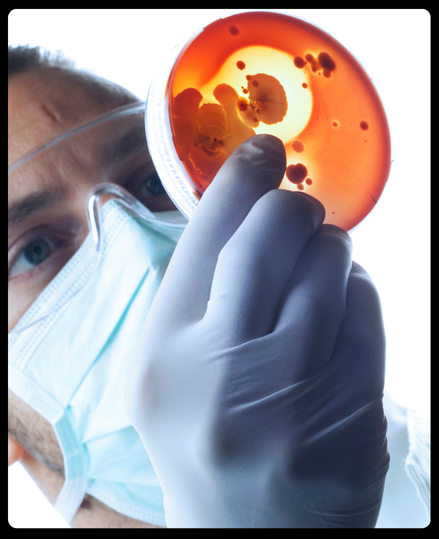

Sova X Started With One Question: Why isn’t this working for me?
Like many people, we tried every “gut health” product out there. Bloating. Acne. Brain fog. Low energy. We tried to fix it all but nothing stuck.
Then we looked deeper. And realized the problem wasn’t us. It was that no product was made for us.
Sova X was born to change that with clinically guided testing and truly customized probiotics designed for your biology, not the average.

The Answer Was in Our Gut. We Just Had to Decode It.
That’s where Sova IQ comes in. Our proprietary engine that reads your microbiome like a map.
Powered by deep tech and clinical expertise, Sova IQ analyses your gut data and builds a precision probiotic tailored to your biology and your goals.
This isn’t just personalised, it’s programmable health. Built in under 10 minutes. Made just for you. At scale.
Designed by Scientists. Recommended by Gut Experts
-

SovaIQ at the Core
Our proprietary health engine decodes your gut data to determine exactly what your body needs.
-

Biomarkers, Not Guesswork
Get a formula that works, built from real diagnostics, not trends.
We match your health goals with the microbial gaps holding you back. -

Art of Precision Science
Each and every formulation is produced in micro batches for every individual. Each blend is unique to you and produced only for your health goal
-

Built on India’s Largest Gut Dataset
With 50,000+ profiles and growing, your formula evolves with the science.
What Sets Us Apart
Build For Your Body. Backed By Science
Hear from our founders on how Sova X combines cutting-edge science with deep personalisation to transform gut health, one body at a time